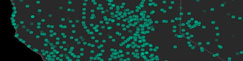
Mapping U.S. Post Offices in the Nineteenth-Century West

This website is no longer updated and has been replaced with a static copy. The Spatial History Project was active at Stanford University from 2007-2022, engaging in dozens of collaborative projects led by faculty, staff, graduate students, post-docs, visiting scholars and others at Stanford and beyond. More than 150 undergraduate students from more than a dozen disciplines contributed to these projects. In addition to a robust intellectual exchange built through these partnerships, research outputs included major monographs, edited volumes, journal articles, museum exhibitions, digital articles, robust websites, and dozens of lightweight interactive visualizations, mostly developed with Adobe Flash (now defunct). While most of those publications live on in other forms, the content exclusive to this website is preserved in good faith through this static version of the site. Flash-based content is partially available in emulated form using the Ruffle emulator.
Gallery (in rough chronological order)
Visualization of historical data in time and space illuminates patterns of movement and transformation in the past. We are experimenting with visualization as a tool to develop new arguments (and new questions) about historical processes and understandings of major historical events. The following thumbnails represent our complete collection of visualizations and publications (indicated with paper symbol icons) produced in the Spatial History Lab, with the newest ones on top.
Some of the visualizations below are finished presentations of the material; others are working drafts that we are using for research purposes but which are already useful for indicating broad trends and potential connections. Published articles, many of them student-led, explore the value of integrating narrative and visual forms of presentation. We invite you to explore the collection and offer your own perspectives about what they do or do not reveal.
Some of the visualizations below are finished presentations of the material; others are working drafts that we are using for research purposes but which are already useful for indicating broad trends and potential connections. Published articles, many of them student-led, explore the value of integrating narrative and visual forms of presentation. We invite you to explore the collection and offer your own perspectives about what they do or do not reveal.
Conservation Histories of California
Historical Ecology of Upper San Francisquito Creek

Salmon Flu Transmission in Salmon Aquaculture

Mapping Mobility in the Budapest Ghetto

Mapping the Law: The Evolution of Slaughterhouse Space, 1852-1870

Fire Vulnerability in the Oakland Hills: Linking Emergency and Policy Reponses to the 1991 Tunnel Fire

Vulnerability in Construction: An Analysis of Home Developments After the Tunnel Fire

A History of Conservation Land Acquisition in California

The Africans of the Slave Ships Cezar and Brilhante, 1838-1865
Conservation for the land or for the species?

Animal City

A Decade of Fire in Western Australia

Chinese Canadian Immigrant Pipeline, 1912-1923

Chinese Canadian Immigrant Flows, 1912-1923

Reconstructing Conservation History: A link between ecology and history

Arrests of Italian Jews, 1943-1945

The Evolution of the SS Concentration Camp System, 1933-1945
Speculative Spaces: Land Speculation and Social Formation in Two California Counties

The Plays of França Júnior

Cigarette Citadels Bricolage

Vulnerability in Production: Road and Housing Networks

Social Unrest Surrounding Chilean Aquaculture, 2000-2010

Vulnerability in Production: A case study of the Rockridge neighborhood in Oakland, California

Water Vulnerability in the Oakland Hills: Oakland Firestorm, 1991

The Demic Atlas Project: A Non-State-Based Approach to Mapping Global Economic and Social Development

Transcontinental Railroad Development, 1879-1893

Machado de Assis: Memórias Póstumas
A Data Model for Spatial History

Colorado Railroad Accidents, July 1884 - June 1885
Neoliberalism, Civic Participation and the Salmon Industry in Southern Chile
When the Loss of a Finger is Considered a “Minor” Injury
Building the New Order: 1938-1945
Chasing an End to Perpetual Deforestation
Land Speculation in Fresno County: 1860-1891
From Salt Ponds to Refuge in San Francisco Bay

Prostitution in Philadelphia: Arrests 1912-1918

Union Pacific Shipping from Nebraska: East/West

Per Capita Income in the United States: 1880-1910

Population Density in the United States from 1790 to 2000

Union Pacific Shipping from Nebraska: Forwarded/Received

Exports from Colorado by Station in 1885
Trail of Blood

Distributions of Occupations, 1870

The Central Pacific and Transcontinental Eleven Step:
How to Run a Transcontinental Railroad
How to Run a Transcontinental Railroad

The Slave Market in Rio de Janeiro: Movement, Context, and Social Experience
What is Spatial History?

Cattle Production in the American West, 1867-1935

The Rise in the American Railway Union, 1893-1894

Yellow Fever Epidemic of 1850: Scale, Time, and Space

Railroad Repeats: The Alfred A. Hart Photo Project

Patterns of Change in Railroad Company Board Members, 1872-1894

Seeing Space in Terms of Track Length and Cost of Shipping

Rio de Janeiro Historical Address Locator

Tracing Railroad Directors, 1872-1894
Botanizing California

Western Railroads and Eastern Capital: Regional Networks on Railroad Boards of Directors, 1872-1894
The Struggle for Ownership of the San Francisco Bay Area 1769-1972

Lawyers in Rio de Janeiro: Movement in the City Center, 1860-1889
Backend Visualizations
Critical Habitat
Visualizing Sea Level Rise and Early Bay Habitation
Bay Area Conservation and Development

California Railroad Commission,
Station Construction Data, 1850-1900
Station Construction Data, 1850-1900

Rising seas flood a river valley and create San Francisco Bay

Visualizing Sea Level Rise and Early Bay Habitation, 6000 B.P. to Present: The Emeryville Shellmound

Tenement Housing in Rio de Janeiro, 1870s-1880s

Jasper Ridge Bay Checkerspot Butterfly Populations, 1960-1998

Extinctions of Bay Checkerspot Butterfly Populations, 1960-2008

Botanizing California, 1840-2008
A Spatial Approach to California Botanists